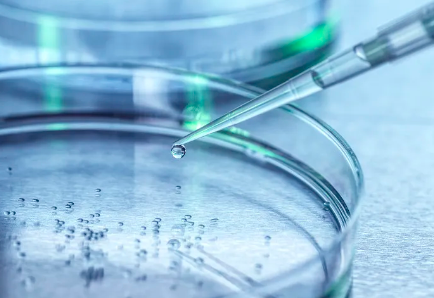
image.png

蘭州哪家醫(yī)院干細(xì)胞捐獻(xiàn)流程最完善?捐獻(xiàn)過(guò)程有哪些注意事項(xiàng)?
2024-11-02 15:43:30 來(lái)源: 小編 咨詢醫(yī)生
干細(xì)胞捐獻(xiàn)是一項(xiàng)拯救生命的重要事業(yè),對(duì)于許多需要干細(xì)胞移植的患者來(lái)說(shuō),選擇一家流程完善的醫(yī)院至關(guān)重要。在蘭州,有許多醫(yī)院都在進(jìn)行干細(xì)胞捐獻(xiàn)工作,那么哪家醫(yī)院的干細(xì)胞捐獻(xiàn)流程最完善呢?下面我們將為您介紹一家流程完善的醫(yī)院,并分享捐獻(xiàn)過(guò)程中的一些注意事項(xiàng)。
首先,蘭州大學(xué)附屬醫(yī)院的干細(xì)胞捐獻(xiàn)流程相對(duì)較為完善。該醫(yī)院擁有一支專業(yè)的干細(xì)胞采集團(tuán)隊(duì),從捐**招募、篩查、采集到后續(xù)的跟蹤服務(wù),每個(gè)環(huán)節(jié)都嚴(yán)格按照國(guó)家相關(guān)規(guī)定和標(biāo)準(zhǔn)進(jìn)行。
以下是捐獻(xiàn)過(guò)程中的一些注意事項(xiàng):
1.了解干細(xì)胞捐獻(xiàn)的基本知識(shí)
在決定捐獻(xiàn)干細(xì)胞之前,捐**應(yīng)充分了解干細(xì)胞的基本知識(shí),包括干細(xì)胞的來(lái)源、采集方式、用途以及可能的風(fēng)險(xiǎn)。這樣,捐**才能在明確自己的意愿后,做出明智的選擇。
2.選擇合適的捐獻(xiàn)時(shí)間
捐**需要根據(jù)自己的時(shí)間安排,選擇合適的時(shí)間進(jìn)行干細(xì)胞捐獻(xiàn)。通常情況下,干細(xì)胞捐獻(xiàn)需要2-3天的時(shí)間,捐**應(yīng)確保在捐獻(xiàn)期間能夠保持良好的身體狀態(tài)。
3.保持良好的身體狀態(tài)
在捐獻(xiàn)前,捐**應(yīng)保持良好的身體狀態(tài),避免過(guò)度勞累、飲酒和熬夜。此外,捐**還應(yīng)按照醫(yī)生的建議進(jìn)行相關(guān)檢查,確保身體健康。
4.遵循醫(yī)囑進(jìn)行捐獻(xiàn)
在干細(xì)胞捐獻(xiàn)過(guò)程中,捐**應(yīng)嚴(yán)格遵循醫(yī)生的指導(dǎo),按照規(guī)定的流程進(jìn)行。捐獻(xiàn)過(guò)程中可能會(huì)出現(xiàn)一些不適,如頭暈、惡心等,捐**應(yīng)及時(shí)告知醫(yī)生,以便醫(yī)生采取相應(yīng)的措施。
5.保持良好的心理狀態(tài)
干細(xì)胞捐獻(xiàn)是一項(xiàng)具有公益性質(zhì)的行為,捐**應(yīng)保持積極向上的心態(tài)。在捐獻(xiàn)過(guò)程中,捐**可能會(huì)面臨一些壓力,如擔(dān)心采集過(guò)程中的疼痛、擔(dān)憂捐獻(xiàn)后對(duì)身體的影響等。此時(shí),捐**應(yīng)學(xué)會(huì)調(diào)整自己的心態(tài),相信自己做出的選擇是正確的。
6.關(guān)注后續(xù)跟蹤服務(wù)
捐獻(xiàn)結(jié)束后,捐**應(yīng)關(guān)注醫(yī)院的后續(xù)跟蹤服務(wù)。如發(fā)現(xiàn)身體有任何不適,應(yīng)及時(shí)與醫(yī)院聯(lián)系,尋求幫助。
總之,蘭州大學(xué)附屬醫(yī)院的干細(xì)胞捐獻(xiàn)流程相對(duì)完善,捐**在選擇捐獻(xiàn)醫(yī)院時(shí)可以考慮這家醫(yī)院。在捐獻(xiàn)過(guò)程中,捐**要注意以上提到的注意事項(xiàng),確保捐獻(xiàn)過(guò)程順利進(jìn)行。同時(shí),我們也希望越來(lái)越多的人加入到干細(xì)胞捐獻(xiàn)的行列,為我國(guó)公益事業(yè)貢獻(xiàn)力量。
- 2024-07-23南京軍區(qū)總醫(yī)院干細(xì)胞,南京軍區(qū)總醫(yī)院干細(xì)胞移植怎么樣
- 2024-11-07301醫(yī)院干細(xì)胞治療成功率如何?如何選擇最佳干細(xì)胞治療醫(yī)院?
- 2024-10-23杭州哪家口服干細(xì)胞醫(yī)院效果顯著?如何選擇最佳治療方案?
- 2024-11-16廣州造血干細(xì)胞儲(chǔ)存醫(yī)院排名,如何選擇儲(chǔ)存方案
- 2024-10-29干細(xì)胞技術(shù)國(guó)內(nèi)哪家醫(yī)院技術(shù)好?如何選擇靠譜的干細(xì)胞治療機(jī)構(gòu)?
- 2024-11-26上海干細(xì)胞醫(yī)院機(jī)構(gòu)有哪些,如何選擇專業(yè)可靠的治療機(jī)構(gòu)
- 2024-09-05如何采集造血干細(xì)胞,造血干細(xì)胞采集流程詳解
- 2024-09-27貝拉干細(xì)胞正規(guī)嗎
- 2024-09-12干細(xì)胞十大公司排名,內(nèi)附收費(fèi)明細(xì)表
- 2024-09-16北京干細(xì)胞治療項(xiàng)目收費(fèi)標(biāo)準(zhǔn)出爐
- 2024-07-23干細(xì)胞醫(yī)院有幾家,國(guó)內(nèi)做干細(xì)胞最權(quán)威的醫(yī)院
- 2024-08-21臍帶干細(xì)胞怎樣存儲(chǔ),存儲(chǔ)的作用大嗎
- 2024-09-10采集自體干細(xì)胞的過(guò)程,自體采干細(xì)胞的步驟
- 2024-10-08移植干細(xì)胞手術(shù)全過(guò)程視頻哪里看?步驟有哪些?
- 2024-09-09卵巢早衰干細(xì)胞治療費(fèi)用大概多少
- 2024-10-11沈陽(yáng)哪家干細(xì)胞醫(yī)院招聘?待遇與發(fā)展前景如何?
- 2024-07-21干細(xì)胞豐胸有效果嗎,干細(xì)胞豐胸是什么原理
- 2024-09-05河南肝硬化干細(xì)胞移植醫(yī)院哪家好
